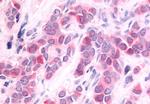
HUNK Antibody in Immunohistochemistry (Paraffin) (IHC (P))

Search
Invitrogen
HUNK Polyclonal Antibody
{{$productOrderCtrl.translations['antibody.pdp.commerceCard.promotion.promotions']}}
{{$productOrderCtrl.translations['antibody.pdp.commerceCard.promotion.viewpromo']}}
{{$productOrderCtrl.translations['antibody.pdp.commerceCard.promotion.promocode']}}: {{promo.promoCode}} {{promo.promoTitle}} {{promo.promoDescription}}. {{$productOrderCtrl.translations['antibody.pdp.commerceCard.promotion.learnmore']}}

Please note: We are reviewing Western blot images included in the antibody testing data in our catalog, including those provided by third parties. Unless expressly labeled or annotated as “raw-unedited”, Western blot images included in the antibody testing data in our catalog may have been edited, optimized or otherwise adjusted for presentation.
产品信息
PA5-33856
种属反应
宿主/亚型
分类
类型
抗原
偶联物
形式
浓度
规格
纯化类型
保存液
内含物
保存条件
运输条件
RRID
产品详细信息
Percent identity with other species by BLAST analysis: Human, Chimpanzee, Gorilla, Gibbon, Monkey, Marmoset (100%).
靶标信息
HUNK serine/threonine kinase or hormonally up-regulated Neu-associated kinase is a member of the mitogen-activated protein kinase family which is essential for mammary tumor metastasis. HUNK deletion in mice did not alter viability, fertility, longevity, or propensity to develop tumors and it is also dispensable for murine development. HUNK has been shown to participate in vesicular transport. Additionally, functional studies in mice suggest that HUNK regulates endocytosis via interaction with rabaptin-5 protein and induces changes in mammary glands during pregnancy. HUNK expression has been documented in mouse brain, breast, embryo, and fetus. ESTs have been isolated from several human tissue libraries, including normal ear.
仅用于科研。不用于诊断过程。未经明确授权不得转售。
篇参考文献 (0)
生物信息学
蛋白别名: B19; Hormonally up-regulated neu tumor-associated kinase; Serine/threonine-protein kinase MAK-V
基因别名: HUNK; MAKV
Entrez Gene ID: (Human) 30811



